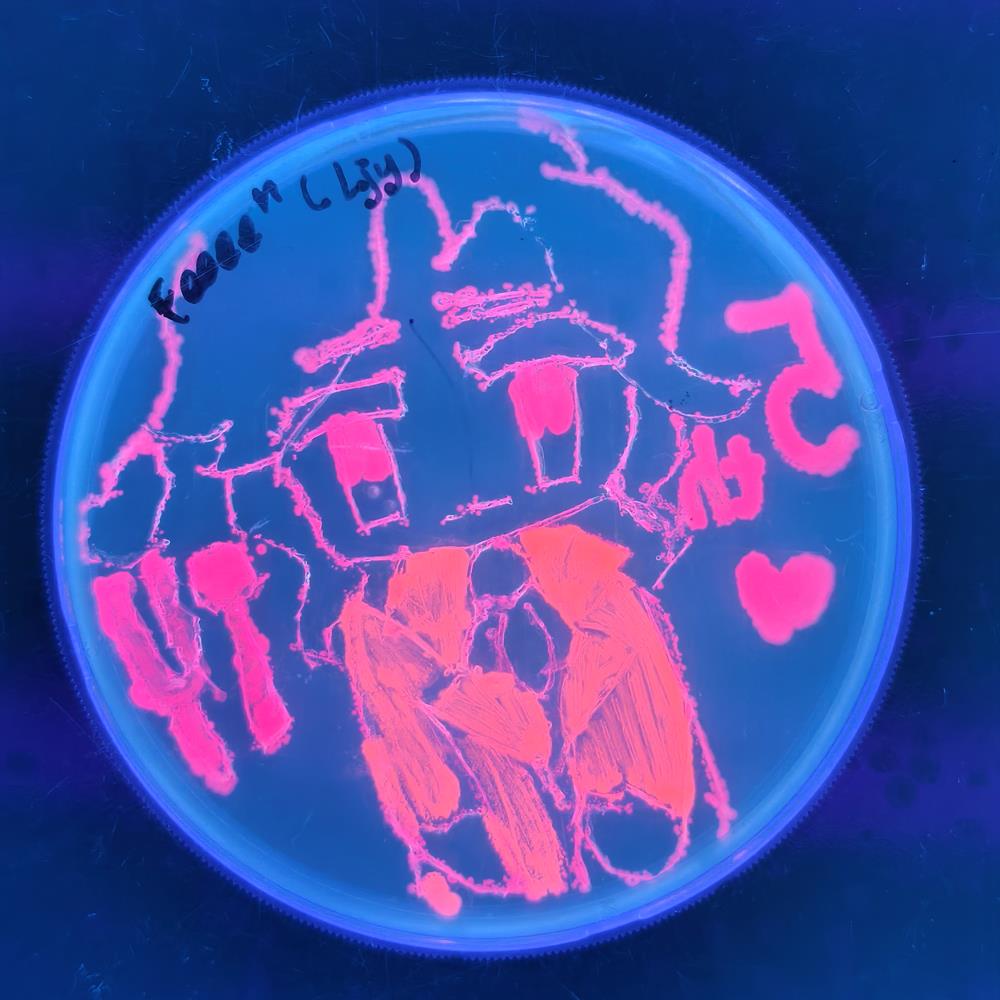
04e44a3430244d53b5810a526bc8f602.jpg

為深入貫徹落實“發(fā)展每一所學校、成就每一位教師、賦能每一位學生”的教育理念,推動拔尖創(chuàng)新人才早期培養(yǎng)工作,2025年12月5日下午,星海教育集團科創(chuàng)學院組織來自星海實驗初級中學、星港學校、星浦實驗中學、星澤實驗學校的29名學生與4名教師,走進冷泉港亞洲D(zhuǎn)NA學習中心,開展主題為“傳承科研精神,探索生命奧秘”的生命科學主題體驗營活動。

在專業(yè)導師帶領下,同學們參觀了中心現(xiàn)代化的教學實驗室,了解基因科學的基礎設施與研究環(huán)境,大家還分組參與了兩項經(jīng)典實驗:

細菌與抗生素實驗:同學們通過親手操作、觀察記錄,直觀理解細菌的結(jié)構(gòu)特性以及抗生素對其生長的影響,在動手實踐中感悟微生物世界的奧秘。


細菌作畫實驗:利用熒光細菌在瓊脂平板上進行藝術(shù)創(chuàng)作,同學們在色彩的鋪陳中學習基因工程的基本原理,感受科學與藝術(shù)交融的無限魅力。

活動全程以“沉浸式實驗+科研思維引導”為主線,摒棄傳統(tǒng)灌輸模式,強調(diào)動手實踐與團隊協(xié)作。同學們在嚴謹?shù)膶嶒灹鞒讨校粌H掌握了科學實驗的基本方法與數(shù)據(jù)記錄規(guī)范,更在互動中體會到科研工作的嚴謹與樂趣。
此次活動拓展寬了學生的科學視野,激發(fā)了學生對生命科學的興趣,同時也為集團持續(xù)推進創(chuàng)新教育、培養(yǎng)未來科學家奠定了扎實基礎。未來,星海教育集團科創(chuàng)學院將繼續(xù)整合優(yōu)質(zhì)科研教育資源,開展更多跨學科、沉浸式科創(chuàng)研學活動,真正實現(xiàn)“賦能每一位學生”,助力他們在科技創(chuàng)新的道路上走得更高、更遠。
撰 稿:顧 維
一審一校:陶秋榮
二審二校:邱明華
三審三校:潘 寧






